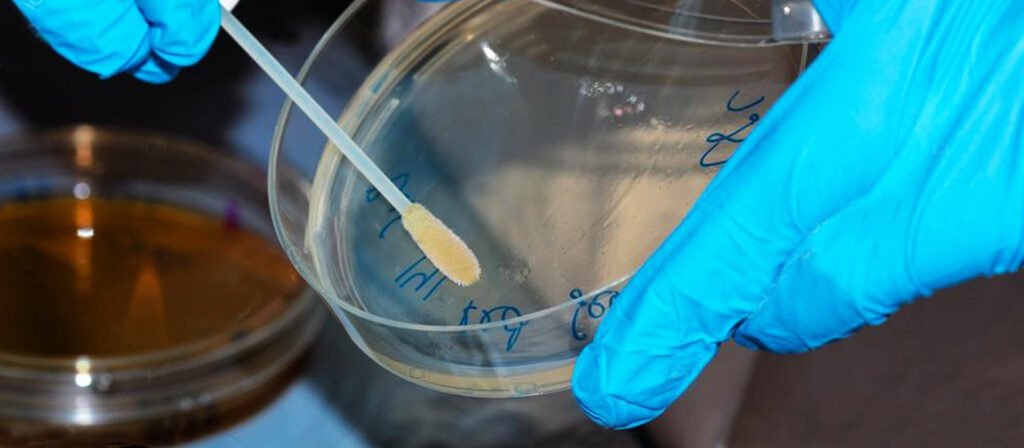

Guia Essencial de Boas Práticas em Laboratórios
Bem-vindos ao nosso guia de boas práticas em laboratórios, um recurso indispensável para profissionais e estudantes que buscam manter um ambiente de trabalho seguro, eficiente e ético. Laboratórios são espaços de inovação e descoberta, mas também podem ser locais de riscos significativos se não forem gerenciados adequadamente. Este guia oferece um panorama das melhores práticas para garantir não apenas a segurança, mas também a integridade e a qualidade dos trabalhos realizados em laboratórios.

Segurança Pessoal: Prioridade Máxima
A segurança pessoal é a espinha dorsal de um laboratório eficiente. O uso de EPIs (Equipamentos de Proteção Individual) é obrigatório. Óculos de proteção, luvas, jalecos e calçados apropriados devem ser utilizados em todas as atividades. Além disso, é fundamental estar familiarizado com os procedimentos de emergência, como lavagem ocular e chuveiros de segurança, e saber como agir em caso de acidentes.
Manuseio e Manutenção de Equipamentos
Equipamentos de laboratório são essenciais para a realização de experimentos. O uso incorreto pode resultar em dados imprecisos ou até mesmo acidentes. Portanto, é crucial seguir as instruções de operação e realizar manutenções regulares. Além disso, a calibração periódica dos equipamentos é vital para garantir a precisão dos resultados.
A realização de atividades práticas no laboratório permite uma aprendizagem mais completa do aluno em todas as fases do ensino. No ensino superior, na área de microbiologia o laboratório requer atenção especial devido aos riscos biológicos na qual o usuário está exposto. O manuseio de equipamentos de laboratório e reagentes químicos sempre apresenta risco. Um laboratório é um ambiente interessante pelas inúmeras possibilidades de conhecimentos e descobertas que oferece.
Para realizar essas experiências laboratoriais, cuidados devem ser tomados, como o perigo de acidentes causados por falha humana ou pela falha técnica de materiais e equipamentos para laboratório.
O risco de acidentes no laboratório pode vir sob algumas formas:
Risco Físico:
Equipamentos para laboratório com elevada fonte de calor e temperatura.
Risco Químico: Reagentes químicos podem ser inalados, aspirados ou ingeridos;
Risco Biológico: Bactérias, vírus, parasitas e outros agentes de risco são capazes de levar o usuário do laboratório a contrair sérias doenças.
As Boas Práticas Laboratoriais determinam que:
- Após cada utilização os equipamentos de laboratório devem ser higienizados;
- As superfícies de trabalho devem ser descontaminadas, pelo menos, uma vez ao dia e sempre depois de qualquer derramamento de material;
- A limpeza da área geral do laboratório deve ser realizada por pessoal treinado e informado sobre as normas de biossegurança, usando EPI adequado;
- Os resíduos sólidos ou líquidos de material patogênico devem ser inativados ou descontaminados antes de serem descartados corretamente;
- Material perfuro-cortante e vidrarias de laboratório quebradas deve ser descartado em recipientes apropriados e resistentes a perfuração.
Estufa para laboratório, banho maria para laboratório, centrífuga sorológica, entre outros) semanalmente pano limpo e seco ou toalha de papel;
Remover a poeira da superfície e partes abertas.após o uso ou em caso de derramamento de substâncias ou contaminação : Água, sabão e álcool a 70%;
Limpar os aparelhos de laboratório com um pano úmido com sabão; retirar o sabão com um pano
umedecido somente com água; aplicar a solução de álcool 70% e deixar agir por 15 minutos; secar com pano limpo ou papel absorvente;
Gestão de Produtos Químicos e Resíduos
Todo laboratório deve ter um sistema eficiente para o armazenamento de produtos químicos, priorizando a segurança e a acessibilidade. O descarte de resíduos químicos e biológicos também é um aspecto crítico e deve seguir as regulamentações locais e nacionais para proteção ambiental e saúde pública.
Documentação e Registro de Dados
A documentação detalhada é fundamental em qualquer pesquisa. Mantenha um livro de registros atualizado com todas as atividades, experimentos e observações. A transparência e a precisão nos registros são cruciais para a validade e a replicabilidade dos experimentos.
Higiene e Limpeza
Um ambiente de laboratório limpo é um ambiente seguro. Implementar rotinas regulares de limpeza, descontaminação de superfícies e equipamentos após cada uso, e manter o laboratório organizado são práticas essenciais para a manutenção de um ambiente de trabalho higiênico e eficiente.
Treinamento e Educação Contínua
A formação contínua é um pilar central nas práticas de laboratório. Investir em treinamento e atualização constante para a equipe garante não apenas a segurança, mas também a eficiência e a inovação no ambiente de trabalho.
Conclusão:
As boas práticas em laboratórios são fundamentais para a segurança, eficácia e integridade da pesquisa científica. Adotar essas práticas não é apenas uma questão de cumprir regulamentos, mas também um compromisso com a excelência
Dúvidas entre em contato conosco.
Participe do nosso blog, envie seu comentário, dúvida ou sugestão.
AVISO DE DIREITOS AUTORAIS: Todo o material deste blog, sendo proibida toda e qualquer forma de plágio, cópia, reprodução ou qualquer outra forma de uso.
Qualquer dúvida técnica sobre os equipamentos contidos no portfólio SPLABOR, entre em contato com o Departamento de Vendas (sp@splabor.com.br)

A Splabor é uma empresa líder no ramo de fabricação de equipamentos para laboratório, especializada em oferecer uma ampla variedade de equipamentos para laboratórios, materiais e produtos para laboratório de alta qualidade.